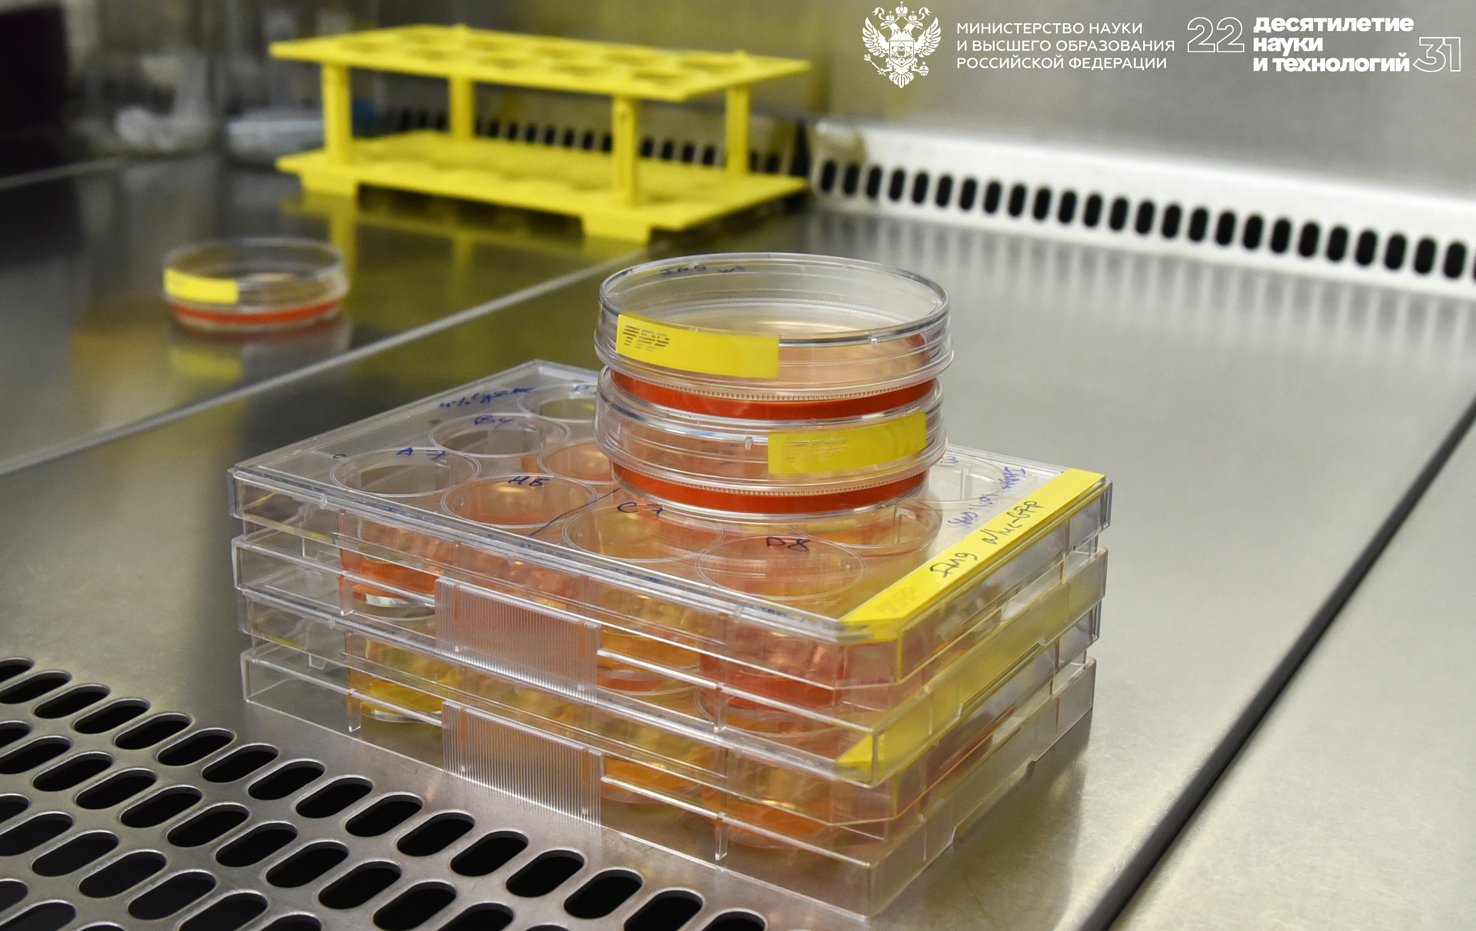
CAR-T.jpg

Биолюминесценция обеспечит быстрый и точный контроль эффективности терапии рака
Сайт Наука в Сибири 14 ноября 2025 г.
Сайт Российской Академии наук 14 ноября 2025 г.
Информационное агентство ТАСС 14 ноября 2025 г.
Сайт Наука.рф 14 ноября 2025 г.
Сайт Сибирская наука 14 ноября 2025 г.
Сайт Сибирского отделения РАН 15 ноября 2025 г.
Исследователи из Института молекулярной и клеточной биологии СО РАН и Новосибирского государственного университета создали новый инструмент для оценки эффективности CAR-T-терапии. Технология основана на применении особого белка — люциферазы, который заставляет раковые клетки светиться, делая их легко видимыми для приборов. Результаты опубликованы в журнале Гематология и трансфузиология.
CAR-T-терапия — это современный метод лечения онкологических и ряда других заболеваний. Принцип его работы следующий: сначала у больного забирают часть собственных иммунных Т-клеток, затем с помощью специальных псевдовирусных частиц в клетки внедряют генетический код, заставляющий их производить особый белок-рецептор (CAR). Этот рецептор распознает определенный сигнал-маркер, расположенный на поверхности клеток. Такая терапия больше всего эффективна при онкогематологических заболеваниях (раке крови).
Большинство солидных опухолей (плотных образований, имеющих четкую локализацию) удобно изучать, вводя их мышам подкожно и замеряя рост обычным штангенциркулем. Однако при заболеваниях крови, таких как лейкоз, опухолевые клетки распространяются и циркулируют по всему организму. Оценить их количество можно только путем полного обследования пациента, когда мы говорим о человеке, а если речь идет про модельных животных — вообще невозможно прижизненно. Исследователи из ИМКБ СО РАН создали метод удобного контроля эффективности терапии на модельных животных при помощи люциферазы — фермента, который в ходе биохимической реакции вызывает свечение.
“Сначала мы прививаем мышам линию клеток человеческого острого лимфобластного лейкоза, постоянно содержащих люциферазу. После введения в организм мыши субстрата, необходимого для активации фермента, клетки начинают интенсивно светиться. Специальный прибор для визуализации (IVISSpectrum) записывает это свечение, вычисляя количество испущенных каждым участком тела фотонов. Аппарат одновременно проводит два типа съемки: обычный рентгеновский снимок и запись люминесценции. Последняя дает наглядную картину локализации опухолевых клеток. Далее специализированная программа рассчитывает количество и местоположение испущенных фотонов, создавая своеобразные карты свечения, отражающие распределение опухолевых клеток. Графики и таблицы позволяют наглядно представить, как изменяется численность таких клеток в зависимости от условий эксперимента и вида терапии”, — рассказывает научный сотрудник лаборатории инженерии антител ИМКБ СО РАН Татьяна Николаевна Беловежец.
Люциферазы используются в науке давно, но чаще всего применяется флуоресценция. Однако у нее есть недостаток: ее свет плохо проходит через ткани организма и плохо фиксируется приборами. Дело в том, что длина волны флуоресцентного света большая, а сила самого сигнала слабая. Совсем другое дело — люминесценция. Ее сигналы имеют меньшую длину волны (они голубоватого цвета), зато энергия намного мощнее. Благодаря этому свет легче проникает через ткани и четко улавливается прибором.
Исследователи выбрали люциферазу NanoLuc, которая светится гораздо ярче обычного, почти в десять раз сильнее, чем похожие ферменты. Благодаря этому стало возможным увидеть даже самые маленькие группы опухолевых клеток. Ученые отметили, что исходно такая люцифераза не функционирует самостоятельно в организме. У морской креветки, откуда белок взят, активность проявляет суммарный комплекс белков.
“Наше исследование показало, что NanoLuc отлично подходит для таких задач. Одно из главных преимуществ — она работает независимо от уровня АТФ (молекула, обеспечивающая энергию в клетках). Обычно, если условия неблагоприятные (например, внутри самой опухоли), АТФ расходуется быстрее, и обычные типы люцифераз тускнеют, но NanoLuc стабильно светится, даже если клеткам тяжело. Всего десять опухолевых клеток успешно обнаруживаются нашим прибором, демонстрируя слабый, но заметный сигнал. Уже сотня клеток создает яркий источник света, позволяющий уверенно определить их положение. Скопление в количестве 10 000 клеток вызывает настолько сильное свечение, что оно превышает чувствительность аппарата”, — отметил исполняющий обязанности заведующего лабораторией биосенсорных технологий НГУ кандидат биологических наук Сергей Викторович Кулемзин.
Ученые предлагают сначала создавать панель, содержащую образцы различных клеточных линий, каждая из которых помечена люциферазой. По интенсивности свечения можно оценивать относительную активность каждой линии. Далее, основываясь на полученных результатах, следует провести параллельные испытания на мышах. После того как зафиксированы показатели свечения у животных, устанавливается точная зависимость между уровнем сигнала и количеством опухолевых клеток в организме. Такой метод обеспечивает создание надежной количественной шкалы, необходимой для точного сравнения результатов различных экспериментов и терапевтических подходов.
“Сегодня в Новосибирске сформировалась группа организаций, заинтересованных в развитии CAR-T-терапии. Среди них Институт молекулярной и клеточной биологии СО РАН, НИИ клинической и экспериментальной лимфологии, НИИ фундаментальной и клинической иммунологии, а также Новосибирский государственный университет. Сотрудничество между этими учреждениями постепенно укрепляется, несмотря на значительную стоимость подобных проектов, в том числе за счет государственного финансирования: программы “Приоритет-2030” (НГУ), государственного задания ФНИ FWNR-2025-0014 (НИИКЭЛ — филиал ФИЦ ИЦиГ СО РАН) и в рамках развития научного центра мирового уровня “Высокотехнологичная биоэкономика” (ФИЦ ИЦиГ СО РАН). Объединяя усилия специалистов разного профиля, мы получаем возможность взглянуть на проблему с разных точек зрения. Сейчас мы разработали инструмент, позволяющий в ходе любого эксперимента оперативно определять остаточное количество опухолевых клеток. Следующим этапом нашей работы станет создание эффективных инструментов для совершенствования технологий CAR-T-терапии и моделирования патологических процессов”, — подытожил Сергей Кулемзин.
Материал подготовлен при поддержке гранта Минобрнауки России в рамках Десятилетия науки и технологий.
Ирина Баранова